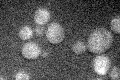
YGR122W

View description
Probable ortholog of A. nidulans PalC, which is involved in pH regulation and binds to the ESCRT-III complex; null mutant does not properly process Rim101p and has decreased resistance to rapamycin; GFP-fusion protein is cytoplasmic
Localization:
Intensity:
Fold change:
Significance:
-
C’ GFP library in SD

cytosol20.22 -
N' NOP1pr-GFP in SD

cytosol73.7793 -
N' TEF2pr-mCherry in SD

cytosol94.2175 -
N' NATIVEpr-GFP in SD

below threshold27.7241 -
N' TEF2pr-VC and Cyto-VN in SD

cytosol39.6085 -
C’ GFP library in SD+DTT

cytosol28.391.4No -
C’ GFP library in SD+H2O2
cytosol22.611.11No -
C’ GFP library in Starvation Media

cytosol200.98No -
C’ GFP library on the background of Pup2-DaMP

N/A -
C’ GFP library on the background of CCT mutant

N/A0N/AYes
